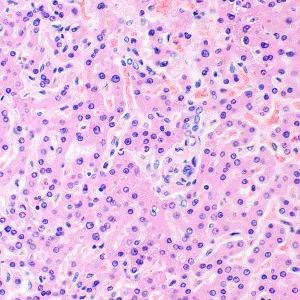
Микроскоп биологический MAGUS Bio 290T, изображение 28

Микроскоп исследовательского класса. Предназначен для наблюдения прозрачных и полупрозрачных биологических образцов в виде мазков и срезов в проходящем свете в светлом поле. Установка опциональных компонентов позволит использовать методы темного поля, фазового контраста, дифференциально-интерференционного контраста, люминесценции и поляризации.
Визуальная насадка
Револьверное устройство и объективы
Дистанционное управление револьверным устройством
Сохранение комфортной яркости при смене увеличений
Фокусировка
Предметный столик
Конденсор
Источник света
Освещение по Кёлеру в проходящем свете
Эргономичная конструкция
Аксессуары
Основные особенности:
Наблюдения прозрачных и полупрозрачных образцов в светлом поле в проходящем свете Тринокулярная насадка с вертикальным тубусом для установки цифровой камеры и изменением угла наклона; переключение светового потока 0/100, 100/0 или 80/20 Моторизированное револьверное устройство – смена рабочего объектива происходит по нажатию кнопки; удобная панель для дистанционного управления револьвером Осветитель проходящего света – экономичный светодиод 3 Вт со сроком службы до 50 000 часов Освещение по Кёлеру в проходящем свете, моторизированный конденсор с откидной линзой Интеллектуальная система управления освещением – автоматический выбор яркости при смене рабочего объектива Предметный столик с пластиной из сапфирового стекла и с длинной ручкой управления для удобной работы Широкая линейка дополнительных аксессуаров Комплектация:
Штатив с механизмом фокусировки, поддержкой функции эко-режима и механизмом полуавтоматического управления револьвером и конденсором
Фонарь светодиодного осветителя проходящего света (установлен на штативе)
Револьвер объективов моторизованный (установлен на штативе)
Держатель столика с кронштейном конденсора
Столик предметный с держателем препаратов
Конденсор Аббе моторизированный с откидной линзой Тринокулярная визуальная насадка Объектив-планахромат Plan 4x/0,10 ∞/–, парфокальная высота 60 мм
Объектив-планахромат Plan 10x/0,25 ∞/–, парфокальная высота 60 мм
Объектив-планахромат Plan 20х/0,40 ∞/0,17, парфокальная высота 60 мм
Объектив-планахромат Plan 40x/0,65 ∞/0,17 (подпружиненный), парфокальная высота 60 мм
Объектив-планахромат Plan 100x/1,25 ми ∞/0,17 (подпружиненный), парфокальная высота 60 мм Окуляр 10x/25 мм с удаленным зрачком и диоптрийной коррекцией (2 шт.) Наглазник на окуляр (2 шт.) Адаптер C-mount 1х Адаптер питания и сетевой шнур питания для микроскопа Пылезащитный чехол Инструкция по эксплуатации и гарантийный талон Поставляются по дополнительному заказу:
Объектив-планахромат Plan 2х/0,06 ∞/–, парфокальная высота 60 мм
Объектив-планахромат Plan 60х/0,80 ∞/0,17, парфокальная высота 60 мм
Объектив план-апохромат Plan Apo 60х/1,42 ми ∞/0,17, парфокальная высота 60 мм
Объектив-планахромат Plan 100х/1,10 ви ∞/0,17, парфокальная высота 60 мм
Набор объективов люминесцентных план-полуапохроматов Plan S-Apo 4х/10х/20х/40х/100х ми ∞/0,17, парфокальная высота 60 мм
Окуляр 10х/22 мм со шкалой
Окуляр 10х/22 мм с сеткой
Окуляр 10х/22 мм с перекрестьем
Окуляр 12,5x/16 мм (2 шт.)
Окуляр 15х/16 мм (2 шт.)
Окуляр 20х/12 мм (2 шт.)
Окуляр 30х/8 мм (2 шт.)
Фазово-контрастное устройство: фазово-контрастный конденсор, набор фазовых объективов, вспомогательный центрирующий телескоп
Конденсор темного поля NA 0,7–0,9
Конденсор темного поля иммерсионный NA 1,3–1,26
Устройство для работы методом дифференциально-интерференционного контраста (ДИК)
Насадка эпи-люминесцентная (эпи-флуоресцентная) с фонарем ртутной лампы, блоками люминесцентных фильтров и блоком питания ртутной лампы
Насадка эпи-люминесцентная (эпи-флуоресцентная) со светодиодным источником света, блоками люминесцентных фильтров и кабелем питания
Устройство простой поляризации
Цифровая камера
Калибровочный слайд
Монитор
Набор светофильтров (голубой, зеленый, желтый, матовый)